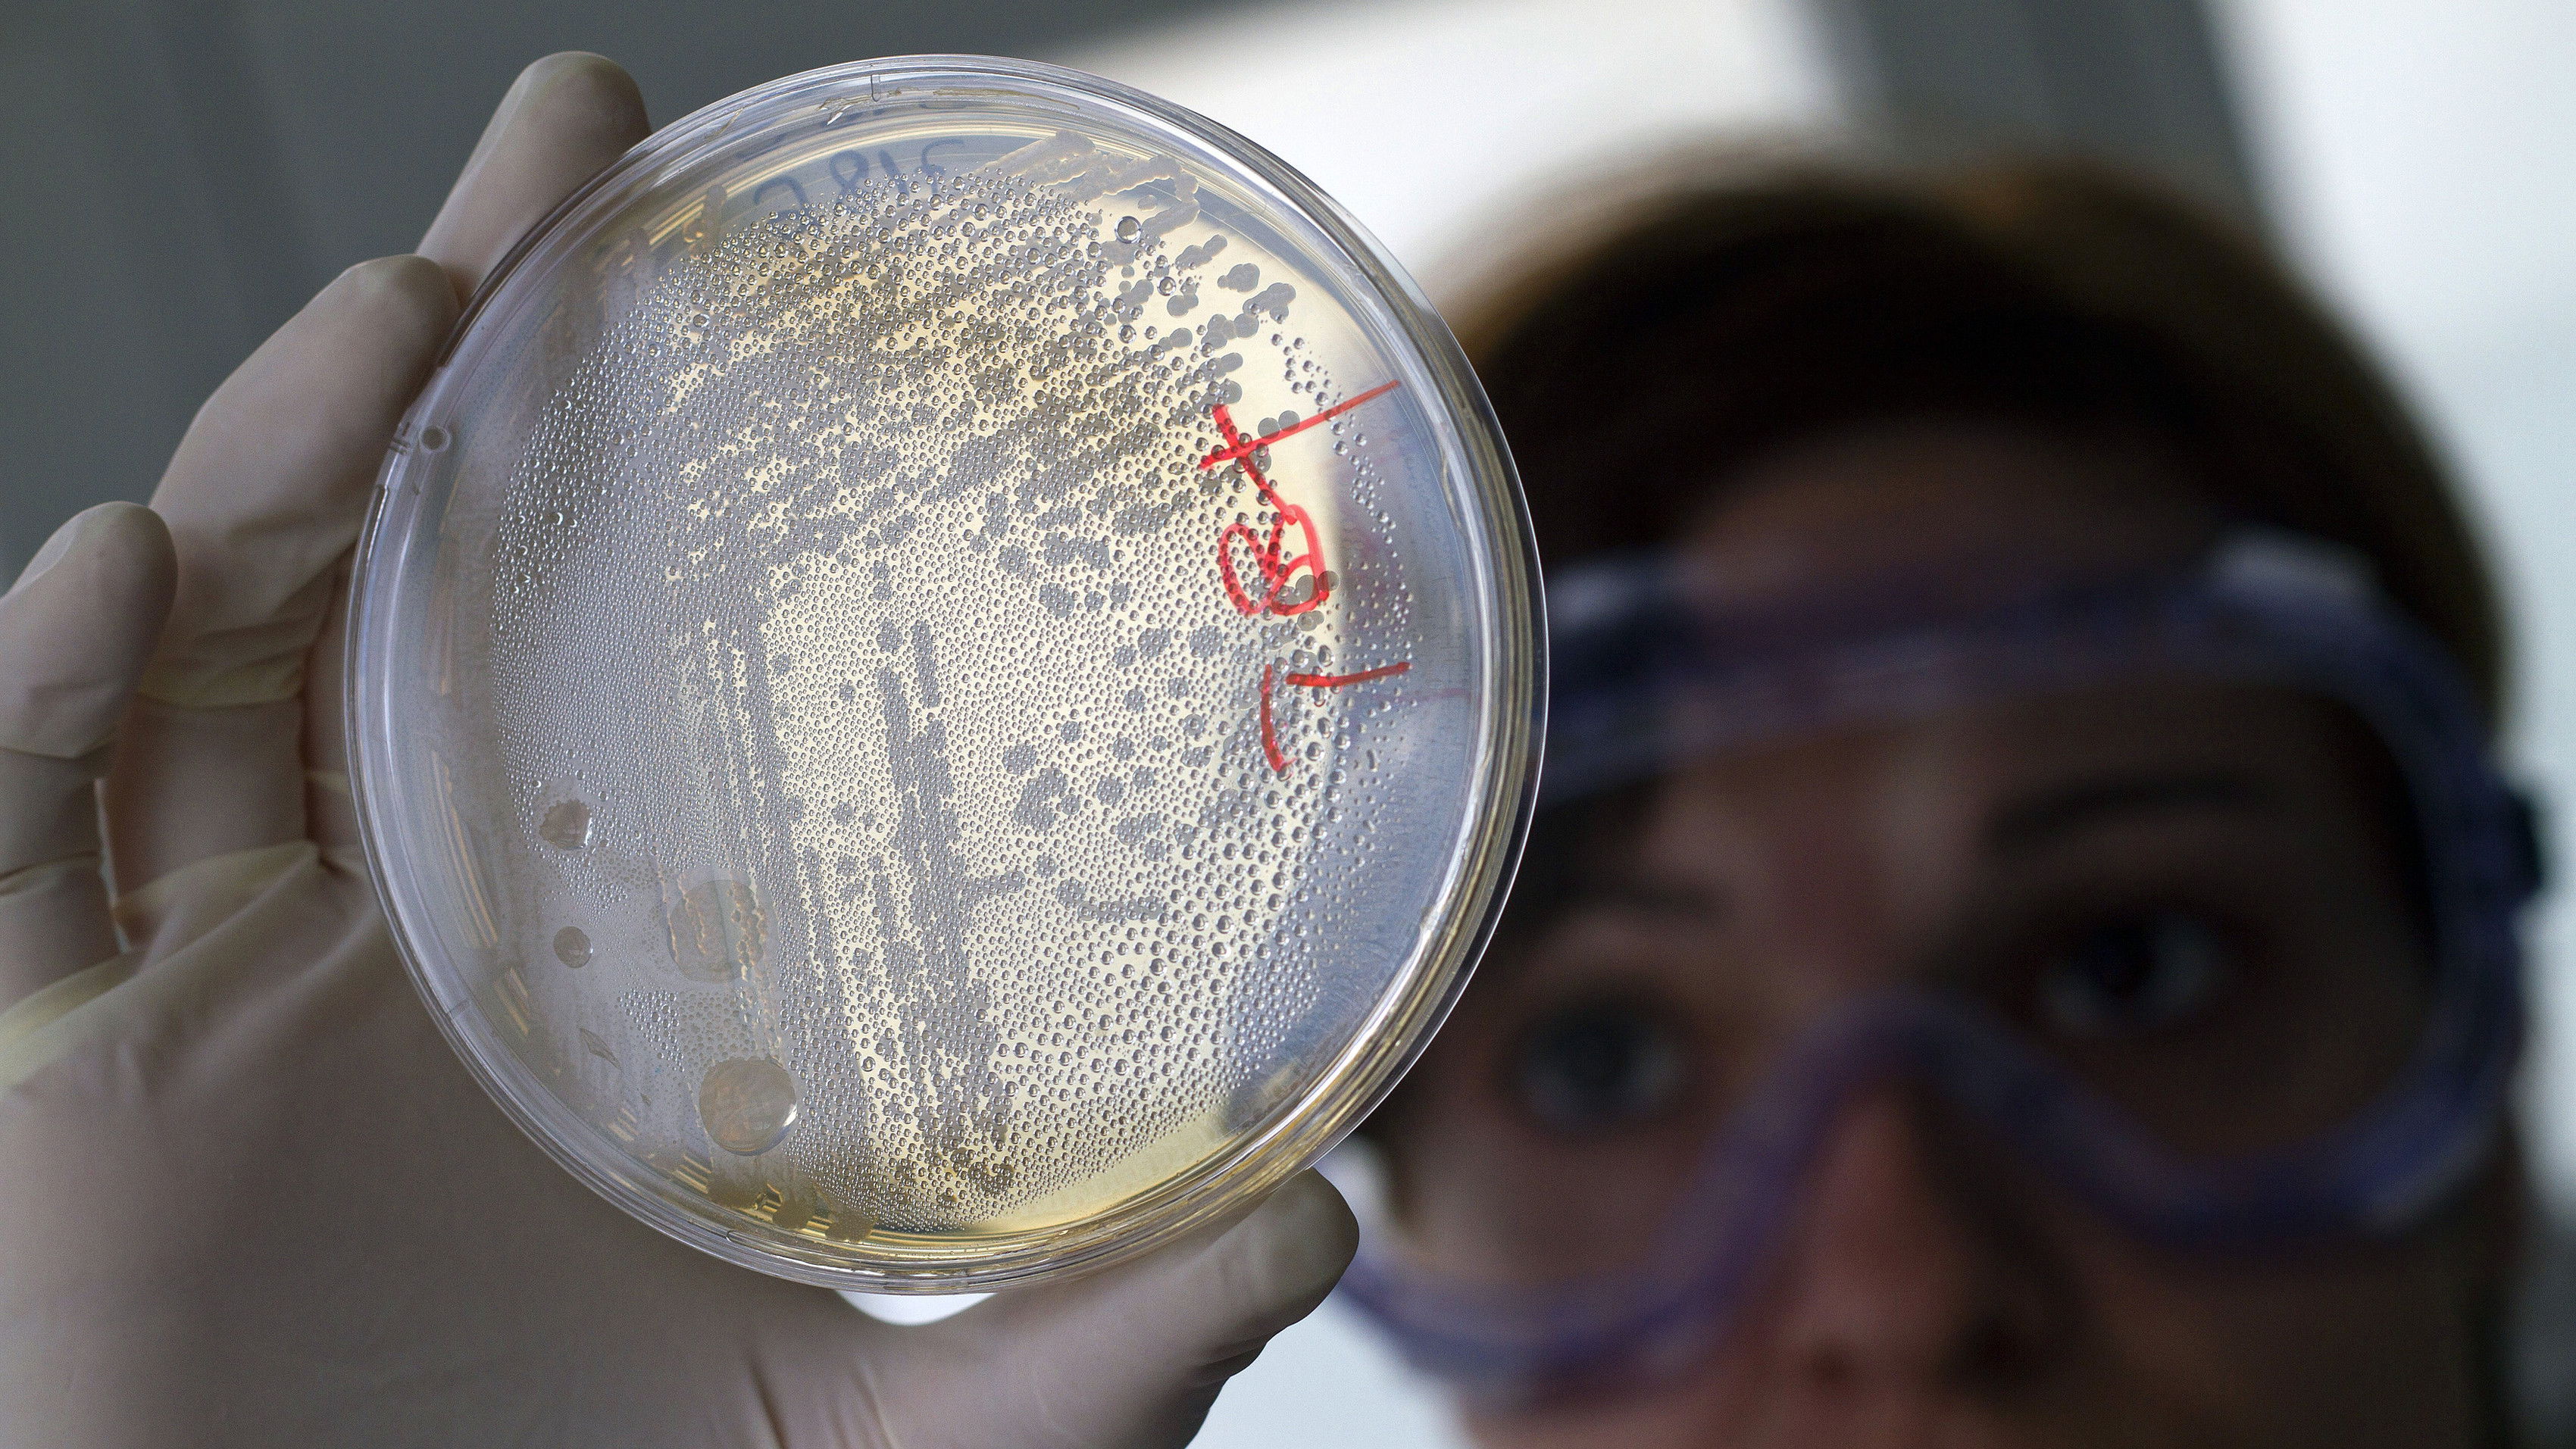
March 28, 2018

Wednesday on the NewsHour, Kim Jong Un meets with Chinese President Xi Jinping, in his first trip outside of North Korea since becoming its leader. Also: The Supreme Court takes on gerrymandering, Egyptians head to the polls, Jimmy Carter on the upcoming midterm elections, a Scottish island welcomes refugees and antibiotic use spikes worldwide, flaming superbug fears.